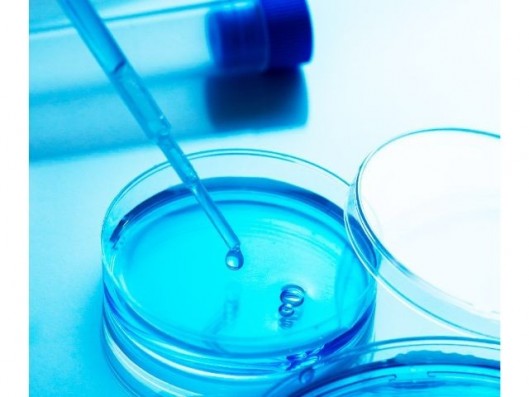
ANÁLISIS DE LEGIONELLA EN...

Desinfección y limpieza
(166 artículos)
Desinfección y Limpieza Dental: Higiene de Superficies e Instrumental
Asegura la máxima higiene en tu gabinete con nuestras soluciones de desinfección y limpieza dental. En DentPro ofrecemos productos de alto espectro de marcas líderes como Durr, ASEPTONET, KDM, Medicaline y StarLine. Nuestro catálogo incluye los productos más vendidos para el mantenimiento de la bioseguridad, desde líquido de desinfección de instrumental con propiedades enzimáticas, hasta desinfectantes de superficies de acción rápida y gran compatibilidad con los materiales del equipo dental. Además, contamos con toallitas desinfectantes listas para usar, ideales para una descontaminación ágil entre pacientes. Encuentra soluciones bactericidas, fungicidas y virucidas que garantizan la eliminación de patógenos y protegen la vida útil de tus instrumentos y mobiliario clínico.